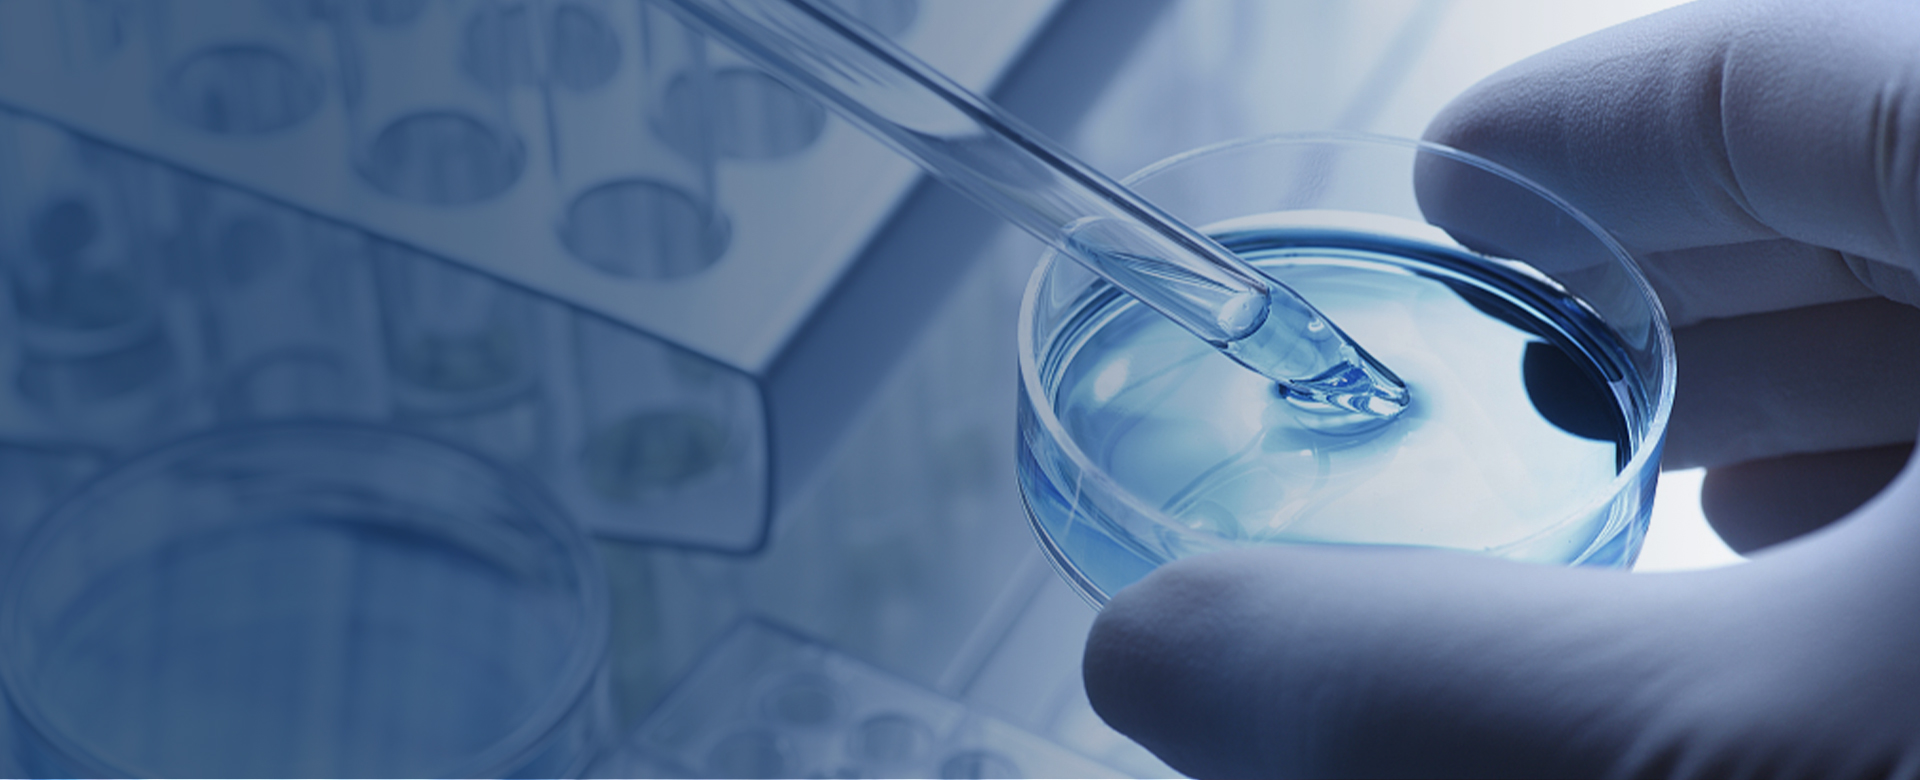
Sequencing Service

-
Products
- Respiratory Pathogens Nucleic Acid Detection CapitalBio
- MAPMI Ultra-Broad-Spectrum Pathogen mNGS Test CapitalBio
- Mycobacteria Nucleic Acid Detection CapitalBio
- Mycobacteria Species Identification CapitalBio
- MTB Drug Resistant Detection CapitalBio
- Human Papillomavirus (HPV) Genotyping Detection CapitalBio
- Six Respiratory Viruses Nucleic Acid Test Kit (PCR-Melting Curve Method) CapitalBio
- Respiratory System Infection Pathogen Targeted Next-generation Sequencing (tNGS) Kit CapitalBio
- Preimplantation Embryo Genetic Screening (PGS) CapitalBio
- Drug-Related Deafness Gene Mutations Detection CapitalBio
- 100 Loci of 18 Deafness-Related Genes Detection CapitalBio
- Hereditary Deafness Gene Detection (227 Genes+Mitochondrial Genome) CapitalBio
- Fetal Aneuploidies (Trisomy 21, Trisomy 18 and Trisomy 13) Detection CapitalBio
- Fetal Chromosomal Aneuploidy and Microdeletions/ Microduplications Detection (NIPT-Plus) CapitalBio
- CNV-seq Detection (Semiconductor Sequencing) CapitalBio
- Karyotype Analysis CapitalBio
- CMA Detection CapitalBio
- Folic Acid Utilization Ability Genetic Detection CapitalBio
- Y Chromosome Microdeletion Gene Detection CapitalBio
- Tandem Mass Spectrometry Screening for Genetic Metabolic Diseases CapitalBio
- DMD (Duchenne muscular dystrophy)/ BMD (Becker muscular dystrophy) Genetic Detection CapitalBio
- 17 Common Single-gene Disorders CapitalBio
- Neuromuscular Disorders CapitalBio
- Epilepsy-related Gene Detection CapitalBio
- GJB2 Gene Coding Region and Splicing Site Detection CapitalBio
- Human Mitochondrial Genome Detection CapitalBio
- Clinical WES CapitalBio
- Individual WES CapitalBio
- WES+CNV-seq CapitalBio
- Precise Diagnosis and Treatment for Brain Cancer CapitalBio
- Targeted Medication Guidance for Lung Cancer CapitalBio
- Targeted Medication Guidance for Colorectal Cancer CapitalBio
- Individualized Medication Guidance for Gastrointestinal Cancer CapitalBio
- Genetic Testing for BRCA1/2 Targeted-Drug Guidance (Germline + Somatic) CapitalBio
- Individualized Medication Guidance for Breast Cancer CapitalBio
- Individualized Medication Guidance for Gynecologic Cancer CapitalBio
- Breast Cancer Prognosis Assessment CapitalBio
- Genetic Testing for Hereditary Breast/Ovarian Cancer(BRCA1/2) CapitalBio
- Individualized Medication Guidance for Prostate Cancer CapitalBio
- Genetic Testing for Blood Cancer CapitalBio
- Individualized Chemotherapy Drugs For Cancers (10 Genes) CapitalBio
- Individualized Medication Guidance for Cancer (800 Genes) CapitalBio
- The Disease Susceptibility Genetic Test-Lung Cancer CapitalBio
- The Disease Susceptibility Genetic Test-Liver Cancer CapitalBio
- The Disease Susceptibility Genetic Test-Stomach Cancer CapitalBio
- The Disease Susceptibility Genetic Test-Breast Cancer CapitalBio
- The Disease Susceptibility Genetic Test-Colorectal Cancer CapitalBio
- The Disease Susceptibility Genetic Test-Esophageal Cancer CapitalBio
- The Disease Susceptibility Genetic Test-High Incidence Cancer (6 Items) CapitalBio
- The Disease Susceptibility Genetic Test-High Incidence Cancer (10 Items) CapitalBio
- The Disease Susceptibility Genetic Test-Cancer Screening Package (29 Items) CapitalBio
- The Disease Susceptibility Genetic Test-Anti-Cancer Package A CapitalBio
- The Disease Susceptibility Genetic Test-Anti-Cancer Package C CapitalBio
- The Disease Susceptibility Genetic Test-Alzheimer's Disease CapitalBio
- The Disease Susceptibility Genetic Test-Thrombotic Disorders (5 Items) CapitalBio
- The Disease Susceptibility Genetic Test-Diabetes (4 Items) CapitalBio
- The Disease Susceptibility Genetic Test-Cardiovascular Disease (14 Items) CapitalBio
- The Disease Susceptibility Genetic Test-Chronic Disease Package (34 Items) CapitalBio
- The Disease Susceptibility Genetic Test-Chronic Disease Package (63 Items) CapitalBio
- The Disease Susceptibility Genetic Test-APOE CapitalBio
- The Disease Susceptibility Genetic Test-ADIPO CapitalBio
- The Disease Susceptibility Genetic Test-Full Package (150 Items) CapitalBio
- The Disease Susceptibility Genetic Test-Obesity CapitalBio
- The Disease Susceptibility Genetic Test-High Myopia CapitalBio
- Metabolic Testing-Alcohol Metabolism Test CapitalBio
- Metabolic Testing-Tobacco Damage CapitalBio
- Metabolic Testing-Alcohol Damage CapitalBio
- Metabolic Testing-Food Intolerance (50 Items) CapitalBio
- Metabolic Testing-Food Intolerance (101 Items) CapitalBio
- Intestinal Flora Testing CapitalBio
-
Sequencing Service
- Agricultural SNP Microarray
- Illumina 850K Methylation Microarray DNA Methylation Sequencing
- Human SNP Microarray
- Resources
- About CapitalBiotech
- Contact Us
 EN
EN